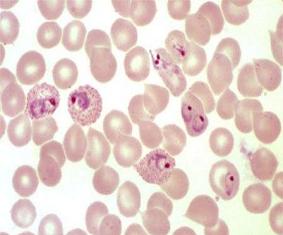

Pesquisa investiga novos microorganismos com potencial probiótico a partir de amostras biológicas de origem animal
O uso de microorganismos para promoção da saúde humana avançou significativamente nos últimos anos. Conhecidos como probióticos, esses microrganismos podem ser utilizados no tratamento de várias doenças gastrointestinais, incluindo a doença inflamatória intestinal, síndrome do cólon irritável e diarreia associada ao uso de antibióticos.
O uso de microorganismos para promoção da saúde humana avançou significativamente nos últimos anos. Conhecidos como probióticos, esses microrganismos podem ser utilizados no tratamento de várias doenças gastrointestinais, incluindo a doença inflamatória intestinal, síndrome do cólon irritável e diarreia associada ao uso de antibióticos.
Algumas bactérias que apresentam o metabolismo do ácido lático (homofermentadoras) são normalmente encontradas no trato gastrointestinal de animais e têm potencial para serem utilizadas como probióticos, especialmente em produtos fermentados de uso diário.
No entanto, segundo especialistas, é preciso comprovar a eficácia desses microrganismos na prevenção ou no controle contra certos enteropatógenos. “É necessário comprovar também a capacidade desses probióticos se estabelecerem efetivamente no trato intestinal juntamente com outros microrganismos pré-existentes da microbiota normal”, defende professor Valério Monteiro Neto, do Uniceuma.
Valério Neto coordena uma pesquisa que pretende investigar novos microrganismos com potencial probiótico para o ser humano a partir de amostras biológicas de origem animal, levando em conta suas características funcionais. “O emprego desses microrganismos oferece uma abordagem inovadora para a concepção de medidas terapêuticas e de controle para doenças específicas”, declarou o professor.
Vantagens
De acordo com Valério Neto, a seleção de novas estirpes de Lactobacillus a partir de amostras de origem animal é de grande interesse para o Brasil, principalmente para o tratamento de uma doença que apresenta elevados índices de morbidade e mortalidade, como é o caso da diarreia. Segundo dados do Unicef, cerca de 1,5 milhões de crianças nesta faixa etária morrem a cada ano vítimas de doenças diarreicas, sobretudo em países em desenvolvimento, caso do Brasil.
Para o pesquisador, a identificação de novas espécies a partir de pesquisas nacionais também ajudaria a diminuir os custos, tornando-os mais acessíveis, além de elevar os indicadores de saúde no país. “Diante da necessidade de alternativas ao tratamento das infecções intestinais, a busca por novos microrganismos com potencial probiótico pode representar um avanço importante para a elevação do nível de saúde entre a população infantil”, disse.
A pesquisa do professor Valério é apoiada pela Fapema por meio do Edital Universal nº 001/2013 e conta com a participação de pesquisadores do Uniceuma, Universidade Federal de Minas Gerais (UFMG), UFMA e UFAM.
